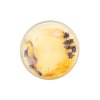
radost candle savon1

Svíčky
Řazení produktů
Výpis produktů

Svíčka AURA je určena pro všechny, kteří mají slabou nebo znečištěnou auru. Čistí a nabíjí energetické pole člověka. Vytváří novou ochranu energetického charakteru. Vyváží nevyvážené a disproporční energie a přivolá nové pozitivní energie. Dodává pocit harmonie, něžnosti, klidu. Doporučujeme pro citlivé osoby, které potřebují posílit svou ochranu. Při pálení této svíčky myslete intenzivně na svou auru jako na energetické vajíčko, které neustále sílí. V mysli posilujte své energetické pole a představujte si, jak roste a jak vás chrání.
- SLOVENSKÝ PRODUKT
- RUČNĚ VYROBENÝ
- 100 % SÓJOVÁ SVÍČKA
- 100 % PŘÍRODNÍ ESENCIÁLNÍ OLEJE
- MINERÁLNÍ KAMENY PRO OSOBNÍ POUŽITÍ

Svíčka je určena k energetické harmonizaci člověka. Díky esenciálním olejům a polodrahokamům působí nejen na čakry, jako čakrové svíčky, ale i na energetický systém jako celek. Svíčka je spojena s pozitivními energiemi kamenů, které odstraňují stres a napětí, uklidňují emoce a myšlenky. Dává do rovnováhy jednotlivé části energetického systému mezi sebou. Očisťuje energetický systém od blokád a napravuje jeho poškození. Svíčku si můžete zapálit kdykoli budete pociťovat nedostatek energie. Svíčka je ozdobena sušenými květy a bylinkami, jako je orgován, leknín, vlčí mák, sléz.
- SLOVENSKÝ PRODUKT
- RUČNĚ VYROBENÝ
- 100 % SÓJOVÁ SVÍČKA
- 100% PŘÍRODNÍ ESENCIÁLNÍ OLEJE
- MINERÁLNÍ KAMENY PRO OSOBNÍ POUŽITÍ

Přitáhněte si do života štěstí. Svíčka, ve které jsou ukryté účinky polodrahokamů, blahobyt a krása květin a bylin. Podle nás štěstí spočívá v životní rovnováze a v radování se z každodenních maličkostí. Svíčka svými účinky pomáhá v těžkých životních situacích změnit pohled na svět a přetváří negativní myšlení na pozitivní. Svíčku si zapalte vždy, když potřebujete vnést světlo do života. Kdo se cítí být šťastný, štěstí rozdává i kolem sebe.
- SLOVENSKÝ PRODUKT
- RUČNĚ VYROBENÝ
- 100 % SÓJOVÁ SVÍČKA
- 100 % PŘÍRODNÍ ESENCIÁLNÍ OLEJE
- MINERÁLNÍ KAMENY PRO OSOBNÍ POUŽITÍ

Vytvořte si večer poklidnou atmosféru a ponořte se do příjemné vůně svíčky, jejíž energie plamene udělá čas před spaním klidným a příjemným zážitkem. Esenciální oleje vám pomohou navodit uklidňující pocity. Úplné uvolnění může vést k lepší kvalitě a hloubce spánku, a tak se ráno probudíte svěží a plní energie do nového dne. Svíčka je zdobena sušenými květinami a bylinkami, jako je levandule, sedmikráska a heřmánek, přičemž každá z těchto bylin má své specifické uklidňující účinky.
- SLOVENSKÝ PRODUKT
- RUČNÍ VÝROBA
- 100 % SÓJOVÁ SVÍČKA
- 100 % PŘÍRODNÍ ESENCIÁLNÍ OLEJE
- MINERÁLNÍ KAMENY PRO OSOBNÍ POUŽITÍ

Vůně připomínající svěží mořský vzduch naplněný teplými paprsky slunce. Plamen této svíčky vás v mysli přenese na místa, kde se cítíte klidně. Svíčka díky kameni akvamarín dodává odvahu, zlepšuje vnímavost, komunikaci a sebepoznání.
V legendách z dávných dob byl kámen Akvamarín spojován s bohyní moře Amfitrítou, která se podle pověsti zrodila z mořské pěny, a také s pokladem mořských panen. Proto je tento kámen oblíbený u námořníků. Přináší jim štěstí a chrání před nástrahami.
- SLOVENSKÝ PRODUKT
- RUČNĚ VYROBENÝ
- 100 % SÓJOVÁ SVÍČKA
- 100 % PŘÍRODNÍ ESENCIÁLNÍ OLEJE
- MINERÁLNÍ KAMENY PRO OSOBNÍ POUŽITÍ

Nadechněte se svěží mandarinky, uklidňující levandule a citronu a otevřete se nové radosti, která k vám přichází. Kompozice jemné, příjemné vůně a účinků polodrahokamů citrínu a křišťálu dělají z této svíčky účinný prostředek na podporu radosti v životě. Nadechněte se svěží mandarinky, uklidňující levandule a citronu a otevřete se nové radosti, která k vám přichází. Vykouzlete si na rtech úsměv, kterým obdarujete celý svět!
- SLOVENSKÝ PRODUKT
- RUČNĚ VYROBENÝ
- 100 % SÓJOVÁ SVÍČKA
- 100 % PŘÍRODNÍ ESENCIÁLNÍ OLEJE
- MINERÁLNÍ KAMENY PRO OSOBNÍ POUŽITÍ